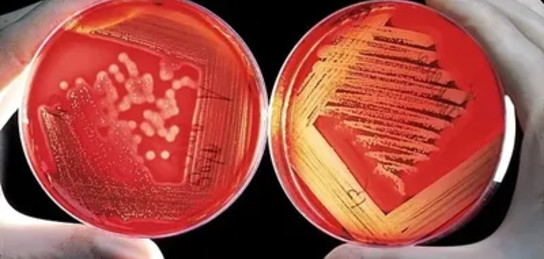

Қытайда чикунгунья безгегін жұқтырудың 1300-ден аса жағдайы анықталды
© Сурет: pixabay
Қытайдың оңтүстігіндегі Гуандун провинциясында чикунгунья безгегінің тағы 1387 жағдайы анықталды, деп хабарлайды Zakon.kz.
Ухань әкімшілігінің баспасөз қызметінің хабарлауынша, ауру жұқтырғандардың көпшілігі (1 212) 2025 жылдың шілде айының басында індет ошағы болған Фошан қаласынан. Гуанчжоу провинциясының әкімшілік орталығында тағы 103 жағдай тіркелді.
Өңірде вирусты тасымалдаушы масаларға қарсы күрес күшейтілгені нақтыланады.
Ауру қазірдің өзінде әлемнің 110-нан астам елінде кеңінен таралған. Қытайда бұл вирустың алғашқы жағдайы 2025 жылдың 8 шілдесінде анықталды.
Бұған дейін Қытайда чикунгунья вирусымен күресу үшін өзен-көл беттеріне жыртқыш масалар жіберілгені хабарланған.
Источник: zakon.kz
Подписывайтесь на наш Telegram-канал. Будьте в курсе всех событий!
Мы работаем для Вас!
Тағы да оқыңыздар:
-
12:27, 20 қараша 2025
Өзбекстанда киберқылмыс өршіп барады
-
17:39, 19 қараша 2025
Таиланд шетелдіктерге қатысты виза режимін қатаңдатты
-
11:15, 18 қараша 2025
Үндістанда хакерлер перзентханалардағы камераларды бұзып, видеожазбаларды әлеуметтік желілерде сатқан
-
11:09, 18 қараша 2025
Бразилияда ежелгі қолтырауын табылды
-
10:34, 18 қараша 2025
Оңтүстік Кореяда ең ірі қалқымалы күн электр станциясы іске қосылды





















